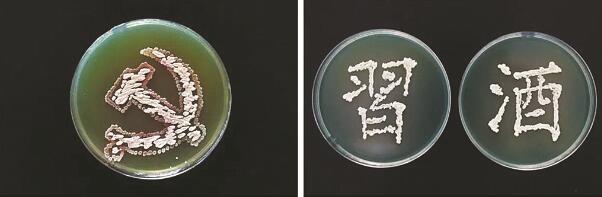
6.jpg
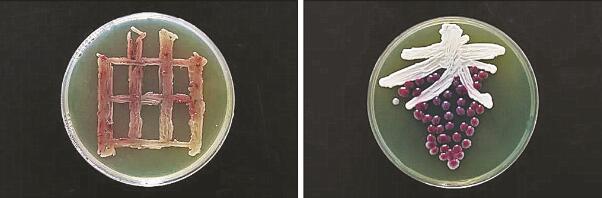
7.jpg
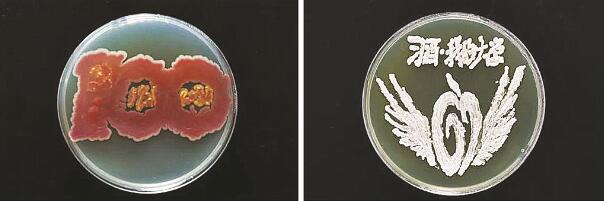
8.jpg
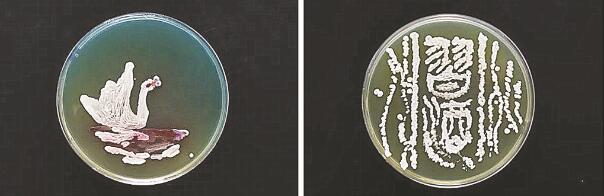
9.jpg
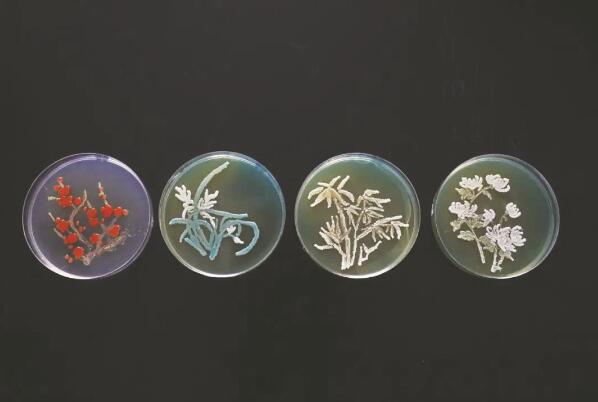
1.jpg
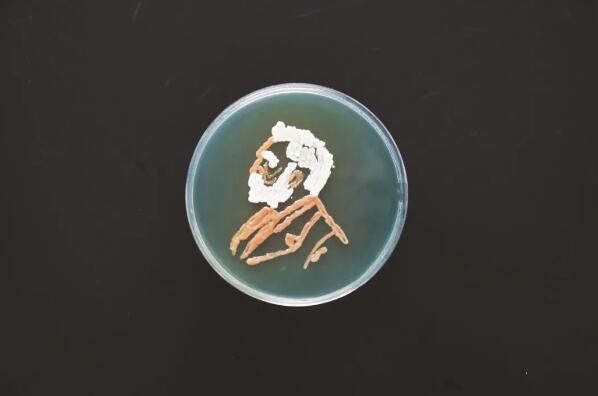
2.jpg

■ 杨先炯 李岭卓 文/图

●部分微生物艺术作品
微生物,一个听起来很神秘的东西。
现实生活中你或许从未与其谋面,又或许只是在显微镜下窥探过它的容颜。然而,在习酒公司众多灵魂画手笔下,它们却摇身一变,成为大众眼前一副副看得见、摸得着的艺术品。
为传播白酒文化,普及微生物相关知识。近段时间,习酒公司技术中心及部分基层团支部组织公司50余名青年员工开展一场别开生面的绘画创作比赛,以9厘米的培养皿做“画布”,微生物做“颜料”,描绘出一幅幅精美的艺术作品。
象征君子四品的梅兰竹菊、陷入沉思的马克思、扬帆起航的习酒文化城……这些都是出自习酒公司的灵魂画手们。


●“灵魂画手”认真创作中
微生物艺术是如何创作的?
在实验室中,各个步骤的无菌操作是对创作者的一大要求。首先,绘画中用到的“画布”培养基、“画笔”接种环、超净台等工具和平台都需要经过高温或紫外线灭菌才能使用。其次,双手需用酒精棉进行擦拭消毒。最后,工作台一直由内而外吹动着净化过的无菌空气,点燃的酒精灯也能形成无菌区域,避免操作过程中杂菌的侵入。
有了这三重无菌保障,再加上一定的微生物操作技能,就可以使用微生物颜料来描绘心中精美的底稿了。
微生物作画不比普通作画,看似简单,其实不然,在进行微生物作画时,不只是选择相应颜色的菌种进行涂抹,还需要了解所用菌种的生长习性,只有了解其生长习性后,这些调皮的微生物才会按照创作者的设想乖乖成长。总之,微生物作画是一项需要耐心、技巧和运气的艺术。

●习酒厂区全貌图
作品图案是怎样形成的?
微生物个体微小,生长代谢非常活跃,但生长总是比较规矩,菌种接种在哪里它就生长在哪里,接种在培养基上的微生物一般2天即可生长成为所需的轮廓。
不同的微生物有着不同的生长习性,如果所选“颜料”是青春烂漫的细菌,需要在37℃条件下培养,如果所选“颜料”是老成持重的酵母菌,那应放在30℃条件下培养,而部分微生物需要4天才能呈现所需的颜色,当轮廓与颜色完美契合,那一副漂亮的微生物艺术品就大功告成了。
●君子风度(梅兰竹菊)
●思考的马克思

●扬帆起航的习酒文化城
微生物对习酒如何产生影响?
别小看这些微生物,它们是酿酒过程中不可或缺的发酵师,决定着习酒独特的风格和优异的品质。
习酒地处东经106°,北纬28°,厂区海拔400米左右,群山环抱,全年气候温和湿润,空气流动慢,无霜期长达300余天,具有冬暖、春早、夏热、秋雨,湿度大、云雾多等特点,这种独特地理环境孕育了丰富的微生物群落,为酒醅发酵提供绝佳条件。本次绘画使用的微生物全都筛选自习酒酿造过程,它们具有不同的形态和大小,颜色各异,功能独特。在它们的共同作用之下,让淀粉糖化、发酵产酒、酯化生香,最终让小麦和高粱变成醇香的美酒。